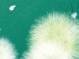

Business and Industry Healthcare




STEAM/Education Finance




Mission Impact


f ree APRIL 2024 voicemagazineforwomen.com $1.95
vibrant
• vocal • vivacious Molly Luton Tonya Triplett Sherri Feathers Crystal Simmons
Subhashini Vashisth Dr. A. Lynn Williams Laken Fritz Judy Miller
Dr. Paula Masters Tina McDaniel


















April 2024 | Volume 21 | Issue 4 www.voicemagazineforwomen.com | April 2024 | 3 Sam Neill Each month Voice will “hide” a picture of a “Hot Hunk.” If you find him, fill out this form, mail it in, and you could win a book from Jan-Carol Publishing! Congratulations to: Clarice Whittaker Kingsport, TN as the winner in the March Hot Hunk Hunt! Thanks to ALL for sending in your entry! (Photo from www.imdb.com) July Hot Hunk Hunt! The April “Hot Hunk” was Robert Downey Jr. on page 31. Name: Address: City: State: Zip Code: Phone Number: Email: HOT HUNK LOCATION: Where did I pick up my copy of Voice Magazine? Mail this submission form to: Voice Magazine P.O. Box 701 Johnson City, TN 37605 or e-mail: hothunk@voicemagazineforwomen.com Deadline for submission is April 20, 2024. PLEASE, ONE ENTRY PER HOUSEHOLD As the selected winner, you must contact Voice Magazine for Women at 423-926-9983 within 90 days to claim and receive your prize. After 90 days, winning becomes null and void and the prize cannot be claimed. April Hot Hunk Hunt! On the Cover free voicemagazineforwomen.com Business and Industry Healthcare STEAM/Education Finance Mission Impact vibrant • vocal • vivacious Luton Tonya Triplett Sherri Feathers Crystal Simmons Subhashini Dr. LynnWilliams Fritz Judy Dr. Masters McDaniel The 2024 YWCA Tribute to Women Award Recipients are featured on our April cover. (Photographs contributed) C M Y CM MY CY CMY K Barter_2024_March_RingofFire_TheVoice_HalfPage.pdf 1 2/12/24 12:18 PM Voice Speaks Janie C. Jessee, Editor-in-Chief 4 Tax Return Extensions 5 Earth Day History 6 Tips on Going Green April Hensley 7 Home Renovations 9 Stress-Free Dinner Party Pam Blair 10 Light and Healthy Salads 11 Announcing 2024 YWCA YWCA Tribute to Women Award Recipients 12 Barter’s Black Stories Black Voices Initiative Serina Marshall 16 JCP New Book Releases 18 Morrison School Field Trip to Meet the JCP Team 22 5 Common Mental Health Conditions 23 Effects of Laughter on the Aging Cindy K. Sproles 24 Voicemale Ken Heath 25 A Season of Renewal Raven Howell 27

Two years ago, we made the announcement of relocating to Blountville, Tenn., into a new office location and a storefront with our books. Our twoyear journey has passed quickly, and it is hard to believe that two years have gone by. We were embraced by the community with welcoming arms, but we are relocating back to Johnson City. We want to thank everyone for their support and hope that they will continue to show support in our move.
Effective May 1, 2024, JCP will be in our new office location. At this time, we are not opening a storefront but will concentrate on promoting our books online and through our online bookstore, which can be found on our website. This will position JCP to look at future options for the company, as well as increase book sales and host author events.
Follow us on our social media and sign up for our weekly newsletter to keep up to date on all our activities. Also, we offer discounts and free items on both. In addition, be sure to follow our book blog and listen to our podcast, which are both called Bookmarked . Our audience for both continues to grow. We interview different authors and guests, and we provide information about the book publishing industry.
As we enter a new chapter in JCP’s story, we are counting on all of you — our readers, supporters, advertisers, business owners, and fans to join us and continue to show your support to JCP and Voice Magazine for Women . Thank you for being there!
From all of us to all of you, we hope you had a Happy Easter and will have a wonderful spring season!
Verse of the month: “Be of good courage, and he shall strengthen your heart, all ye that hope in the Lord.” Psalm 31:24 KJV
Thought of the month: “A woman is like a tea bag — you can’t tell how strong she is until you put her in hot water.” — Eleanor Roosevelt



























4 | April 2024 | www.voicemagazineforwomen.com Janie C. Jessee, Editor-in-Chief VOICE Speaks FREE Serving Northeast Tennessee and Southwest Virginia! voicemagazineforwomen.com • jancarolpublishing.com LITTLE CREEK BOOKS MOUNTAIN GIRL PRESS EXPRESS EDITIONS ROSEHEART PUBLISHING DIGISTYL E FIERY NIGHT SKIPPY CREEK BROKEN CROW RIDGE “every story needs a book Celebrating our 20th anniversary! We wouldn’t be here and there without all of you! PUBLISHER Jan-Carol Publishing, Inc PO Box 701 Johnson City, TN 37605 EDITOR-IN-CHIEF Janie C Jessee, 423.502.6246 publisher@jancarolpublishing.com CONTRIBUTING WRITERS Draco Bailey Communications Director/Production Editor communications@jancarolpublishing.com Allison Chudina Editorial/Retail Assistant office@jancarolpublishing.com GRAPHICS/PRODUCTION Tara Sizemore Senior Graphics Designer tara@voicemagazineforwomen.com graphics@jancarolpublishing.com Office Phone/Fax: 423.926.9983 Books & Gifts: 423.212.0200 DISTRIBUTION Karen Corder Staff PUBLISHED BY JAN-CAROL PUBLISHING, INC. (Volume 21, Issue 4) (Janie Jessee’s Photograph: Rebecca Griffin/London Vine Studios) While every precaution has been taken to ensure accuracy of the published material, Jan-Carol Publishing, Inc. / Voice Magazine cannot be held responsible for opinions or facts provided by its authors, advertisers or agencies. All rights are reserved. Reproduction in whole or part is prohibited without written permission. Agencies, Advertisers and other contributors will indemnify and hold the publisher harmless for any loss or expense resulting from claims or suits based upon contents of any advertisement, defamation, libel, right of privacy, plagiarism and/or copyright infringement. The views expressed in Voice Magazine for Women are not necessarily those of the publisher. © 2024 EDITORIAL MISSION: Voice Magazine for Women wants to provide a useful and complete reliable source of information for women and their families. We seek to celebrate women’s successes, and support their growth by defining and recognizing their needs and providing a concentration of resources for them. We want to be that “link” to all women. Pam Blair Ken Heath April Hensley Raven Howell Serina Marshall Cindy Sproles IF YOU OWN IT, CLAIM IT! SUCCESS! JANIE C. JESSEE was written to inspire and encourage women to seek out their destiny. Author Janie Jessee shares simple truths in starting business or pursuing career dream. Presented in uncomplicated terms, quotes, and verses that will enlighten you, encourage you, and inspire you, this book the perfect read for the beginning entrepreneur or the seasoned business woman needing to be uplifted in simple terms. Born into blue collar working family and raised on farm Southwest Virginia, Janie Jessee was taught values of hard work, rooted in Christian-believing morals. Being part of the baby boomer generation, Jessee supported the old traditions being broken and new traditions being created for women in business family to receive college degree, Jessee was the first to start and CAN $20.00 Purchase Janie C. Jessee’s books, Woman to Woman: If You Own It, Claim it! ($5 includes free shipping) and Gone Before Breakfast ($10 includes free shipping) www.jancarolpublishing.com or call 423.926.9983
What to Know About Applying for an Extension on Your Tax Return
The Internal Revenue Service reports that the deadline to file a 2023 tax return is Monday, April 15, 2024. The vast majority of taxpayers will have no issue filing by the deadline, but some may not be able to file on time. In such instances, taxpayers can apply for an extension of time to file.
An extension is not necessarily as straightforward as the term suggests. In fact, the IRS urges taxpayers to be aware that applying for an extension does not grant taxpayers an extension of time to pay their taxes. Failure to pay by the April 15 deadline could incur penalties, even for people who have applied for an extension. The IRS urges taxpayers to estimate any owed taxes by the deadline and submit payments for those estimates by April 15.
Extension requests must be submitted by the regular return due date.
Some taxpayers may not have to submit an extension return. The IRS notes that taxpayers in certain disaster areas do not need to submit an extension electronically or on paper. For example, the IRS had already determined by February 2024 that Maine taxpayers impacted by severe storms and flooding qualified for tax relief. Various deadlines, including the April 15 filing deadline for individuals and businesses, were extended to June 17, 2024. Maine taxpayers are urged to contact a tax preparation professional to determine if they are eligible for the later deadline. A list of additional extensions affecting the 2024 filing deadline can be found at https://www.irs. gov/newsroom/tax-relief-in-disaster-situations.
Individual taxpayers, regardless of income, can use the IRS Free File (https://www.irs.gov/filing/free-filedo-your-federal-taxes-for-free) to request an automatic tax-filing extension. Filing that form gives taxpayers until October 15 to file a return. If October 15 falls on a Saturday, Sunday or legal holiday, the due date

is extended until the next business day. It’s important that taxpayers filing for the October 15 extension deadline recognize that they must still estimate their tax liability on the Free File form and pay any estimated taxes owed.
The deadline to file a 2023 tax return is Monday, April 15, 2024. Individuals who need more information about applying for an extension are urged to visit irs.gov.

www.voicemagazineforwomen.com | April 2024 | 5 Prices vary by state. Options selected by customer; availability and eligibility may vary. State Farm, Bloomington, IL Call, click or stop by. Create a Personal Price Plan™ Agent 2313 Browns Mill Road Johnson City, TN 37604-1961 Bus: 423-722-AUTO www.sheilawandell.net Sheila Wandell CLU® ChFC®
A Brief History of EARTH DAY
Earth Day is celebrated each April and draws attention to a range of issues affecting the environment. Earth Day aims to raise awareness in the hope of inspiring change.
Earth Day is observed on April 22. According to National Geographic, the first Earth Day was celebrated in 1970. Wisconsin senator Gaylord Nelson was inspired to begin a national celebration uniting the environmental movement after witnessing environmental activism in the 1960s. With the help of Denis Hayes, a graduate student at Harvard University, Nelson organized the first Earth Day. Twenty million people participated in events across the United States and strengthened support for environmental legislation like the Clean Air Act and the Endangered Species Act.
Earth Day was expanded to a global initiative in 1990 under guidance from Hayes. Nearly 200 million participants in more than 140 countries now join together in the name of protecting the planet. Awareness continues to be raised each year regarding renewable energy and climate change.
One of the hallmarks of Earth Day celebrations is the planting of trees. Researchers estimate roughly 15 billion trees are cut down each year across the globe. By planting a tree every Earth Day, people can make a difference. Trees absorb carbon dioxide and release oxygen and bolster ecosystems for wildlife. Shade trees can reduce reliance on fans and air conditioning systems.
The main message of Earth Day 2024 is the need to commit to ending reliance on plastics, says EarthDay. org. The goal is a 60 percent reduction in the production of all plastics by 2040. Plastics are bad for the environment a growing body of research indicates they have an adverse effect on the major systems of the body, including immune, respiratory, digestive, and hormonal systems.
Everyone can do their part to promote the ideals behind Earth Day. For 54 years, millions of people have been advocating for change to benefit the planet and human and animal health, and that fight is ongoing.

We Asked our Facebook Fans:
Spring!
— Kay Davis Flowers, Festivals, Sunshine ��
— Robin Carter Ricker
Spring flowers, sunshine and the lake coming up ������
— Angela Farmer Mayhew
Going to the river and kayaking
— Maya Sizemore
6 | April 2024 | www.voicemagazineforwomen.com
What do you love most about April?
Family-Friendly Tips on GOING GREEN
By April Hensley
You don’t have to go far in today’s technology-driven society to hear about environmental problems. Gardeners and other outdoor lovers get to see the effects more than others. Whether it’s a reduction in the number of bees pollinating our plants or trash polluting our mountains and waterways, we are usually the first to notice.

One of the ways to help is by recycling. Most of us want to do our part. In honor of Earth Day on April 22, here are a few family-friendly tips to help get you started. You might be surprised to learn that you are already doing more than you thought.
1. Use leftover plastic food containers for pots when gardening. Also, old sheets can be used to protect plants against frost. Use worn-out clothes to make a scarecrow for your garden.
2. Paper, plastic, and aluminum are usually recycled at a facility. Check with your town or community to find out the type of collection facilities available.
3. Clothing can be donated to a charity but there may be consignment shops in your area. Some stores pay you a percentage when your item sells and others trade out the value of your clothing. Individual stores will have different policies.
4. You can have an old-fashioned yard sale. Sell unwanted and outgrown things like clothes, toys, books, etc. Remember, one man’s trash is another man’s treasure. Check with your local courthouse for restrictions on yard sales in your area.
5. You can have it repaired. A sagging hem on your favorite pants can be fixed for a few dollars by a local seamstress. Also, vacuum cleaners and other appliances can sometimes be fixed for a fraction of the cost of a new one.
6. Try to buy refills whenever possible. There are a few on the market such as cleaners, soaps, and laundry detergents. This helps cut down on the production of reusable plastic containers. Also, look to buy concentrated formulas and large bottles instead of multiple smaller ones.
7. Talk to your child’s teacher to see if they will be making crafts from recycled materials that you can start saving for the class. Also, look for age-appropriate projects to make with your children such as using old socks to make puppets or snowmen. This will give you quality time with your child while teaching them to use their imagination.

www.voicemagazineforwomen.com | April 2024 | 7
• New Construction • Guttering • Custom Woodworking • Exterior and Interior Remodeling 423.968.5344 Licensed, Insured and Bonded Call Today! • New Construction • Guttering • Custom Woodworking • Exterior and Interior Remodeling Licensed, Insured and Bonded Call Today! 423.968.5344 { April Hensley works as an office manager and is an avid gardener, writer, and greenhouse hobbyist. April loves the outdoors and is passionate about animal welfare and the environment. She can be reached at aprils1105@embarqmail.com.
Tips to Revitalize a Garden this Spring
have lingered into spring and prune any perennials that need it. Branches that fell during winter storms also should be removed at this point if they have not previously been discarded.
Gardening is a rewarding hobby that pays a host of significant dividends. Many people love gardening because it allows them to spend time outdoors, and that simple pleasure is indeed a notable benefit of working in a garden. But the National Initiative for Consumer Horticulture notes that gardening provides a host of additional benefits, including helping people get sufficient levels of exercise, reduce stress and improve mood.
With so much to gain from gardening, it’s no wonder people look forward to getting their hands dirty in the garden each spring. As the weather warms up, consider these tips to help bring a garden back to life.
• Discard the dead weight. Winter can take its toll on a garden, even in regions where the weather between December and early spring is not especially harsh. Discard dead plants that

• Test the soil. Soil testing kits can be purchased at local garden centers and home improvement retailers. Such tests are inexpensive and can reveal if the soil needs to be amended to help plants thrive in the months to come.
• Mulch garden beds. Mulching benefits a garden by helping soil retain moisture and preventing the growth of weeds. Various garden experts note that mulching in spring can prevent weed seeds from germinating over the course of spring and summer. That means plants won’t have to fight with weeds for water when the temperature warms up. It also means gardeners won’t have to spend time pulling weeds this summer.
• Inspect your irrigation system. Homeowners with in-ground irrigation systems or above-ground systems that utilize a drip or soaker function can inspect the systems before plants begin to bloom. Damaged sprinkler heads or torn lines can deprive plants of water they will need to bloom and ultimately thrive once the weather warms up.
• Tune up your tools. Gardening tools have likely been sitting around gathering dust since fall. Serious gardeners know that tools can be expensive, so it pays to protect that investment by maintaining the tools. Sharpened pruners help make plants less vulnerable to infestation and infection. Well-maintained tools like shovels and hoes also make more demanding gardening jobs a little bit easier, so don’t forget to tune up your tools before the weather warms up.
It’s almost gardening season, which means gardeners can start on the necessary prep work to ensure their gardens grow in strong and beautiful this spring.
8 | April 2024 | www.voicemagazineforwomen.com
Renovations that Help Sell Homes
Certain home features can tip the scales in favor of sellers. In fact, various renovations can help sell homes more readily. Putting a home on the market can be stressful, but these renovations may help it sell fast.
• A fresh coat of paint: Although painting is relatively inexpensive and a job that some do-it-yourselfers can tackle, it’s not a task relished by many. Painting is messy, it takes time, and requires moving furniture. In fact, prepping a room for painting often is the toughest component of any painting job. But fresh coats of paint can create a strong first impression. Choose a neutral color and get painting. Jennie Norris, chairwoman for the International Association of Home Staging Professionals, says gray is a “safe” color that has been trending in recent years.

The National Association of the Remodeling Industry estimates that homeowners can recover up to 52 percent of the cost of a kitchen upgrade upon selling a home. Buyers want a functional and updated kitchen. Trending features include drawer-style microwaves and dishwashers, commercial ranges, hidden outlets, and even wine refrigerators.
• Updated heating and cooling system: Better Homes and Gardens reports that homeowners may be able to recoup 85 percent of the cost of new HVAC systems when they sell their homes. Heating, cooling and ventilation components are vital to maintain. You don’t want buyers to be taken aback by an older system, and many millennial buyers are not willing to overlook old mechanical systems.
• Minor bathroom remodel: Remove dated wall coverings, replace fixtures, consider re-glazing or replacing an old tub, and swap old shower doors for fast fixes in a bathroom. If there’s more room in the budget, replacing a tub, tile surround, floor, toilet, sink, vanity, and fixtures can cost roughly $10,500, says HGTV. You’ll recoup an average of $10,700 at resale, making a minor bathroom remodel a potentially worthy investment.
• Redone kitchen: The kitchen tends to be the hub of a home. This room gets the most usage and attention of any space, and it’s a great place to focus your remodeling attention.
• Fresh landscaping: A home’s exterior is the first thing buyers will see. If they pull up to a home with eye-catching landscaping and outdoor areas that are attractive yet functional, they’re more likely to be intrigued. Often buyers will equate a home that features an impressive exterior with upkeep inside as well. The American Nursery Landscape Association says the average homeowner may spend $3,500 for landscaping.
Improving a home’s chances to sell quickly and at a higher price often comes down to making smart improvements that catch the eyes of buyers.


www.voicemagazineforwomen.com | April 2024 | 9
100 Coley St. • Kingsport, TN RealtorRobinMiller@gmail.com www.TennHomestead.com Robin Miller Re al Estate Professional Direct – 423.647.9476 Call Today! Serving the Tri-Cities since 2005 Thinking of Bu ying or Selling?
6 Steps to a
STRESS-FREE Dinner Party
By Pam Blair
Ever wondered how to host a dinner party and enjoy it? Going out to eat at a restaurant makes it so easy — everyone orders a meal, and you don’t have to cook, clear the table, or do the dishes. Restaurants make their money by serving as many people as possible, and that means your meal could be over all too soon. The best conversations often happen when you can linger over a meal and not be concerned that someone is waiting for you to leave. Hosting a dinner party at home may sound like lots of work, but by breaking it down into manageable steps you can do it without being stressed out, and you and your guests will have a great time.


dishes and utensils that will display the food you are serving. Arrange flowers and candles, if used, for your centerpiece.
1. Plan the menu and keep it simple. This is not the time to try a new dish unless you are a very accomplished cook with no fear. If possible, choose a main course that tastes even better when cooked in advance, like a braise or a stew. Read your recipes carefully before you shop, to be sure you don’t miss a key ingredient.
2. Make a checklist. Once you decide on the menu, write it down, along with anything you can do 2–3 days before the party. This will help to keep you organized. Create a timeline for which dishes need to be prepared first and those that can wait. Buying local food, like dessert from a bakery, is okay too!
3. Prepare food in advance. Do as much prep work as possible a day or two early, such as chopping vegetables, marinating meat, and making side dishes like mashed potatoes that can be reheated later. It will feel so good to have this done before the day of the party, when you may be cooking the main dish.
4. Set the table. If you do this a day ahead of time, you can envision what plates, flatware, napkins, and glasses to use. At the same time, pull out any serving
5. Finish the essentials. On the day of the party, you may be preparing the main dish, but start early enough that you are not rushing to finish before guests arrive. If the dish requires a last-minute step, ask someone to keep guests occupied with drinks or conversation so everyone is not standing near the stove with you. Be sure to warm dinner plates in the oven on a low setting (170–200 degrees), which helps to keep food warm after serving.
6. Keep the party going. As the conversation continues to flow, clear the table before dessert, but save the heavy cleanup for later. After everyone leaves, you can load the dishwasher and tidy up as you reminisce about all the fun you had with your friends. Remember, if the host is relaxed and enjoying the evening, your guests will too!

10 | April 2024 | www.voicemagazineforwomen.com
other publications.
Pam Blair is a former medical librarian and communications manager who gets nervous when she doesn’t have something to read. She loves descriptive writing and has authored and edited a book and numerous
Contact her at pblair919@aol.com. {

Bright Spring Salad

Serves 4 Salad
1 bunch asparagus, tender parts, chopped into 1-inch pieces
½ cup frozen peas, thawed
A few handfuls of salad greens
2 radishes, thinly sliced
½ cup crumbled feta cheese
½ avocado, pitted and diced
¼ cup chopped, toasted pistachios
½ cup roasted chickpeas
Fresh herbs, for garnish (basil, mint, and/or chives)
Sea salt and freshly ground pepper
Dressing
¼ cup fresh basil or a mix of basil and mint
1 small garlic clove
1 tablespoon lemon juice, plus ½ teaspoon zest
1 tablespoon white wine vinegar
2 tablespoons extra-virgin olive oil, more as desired
¼ teaspoon sea salt
1. Bring a large pot of salted water to a boil and set a bowl of ice water nearby. Blanch the asparagus for about 1 minute, until tender but still bright green. Transfer to the ice water for 1 minute, then drain. Allow the asparagus to dry and transfer it back to the bowl and add the peas.
2. Make the dressing: In a food processor, pulse together the herbs, garlic, lemon juice, zest, vinegar, olive oil, and salt.
3. Add half of the dressing to the bowl with the asparagus and toss to coat. Season to taste with salt and pepper.
4. Assemble the salad. Arrange the salad greens on a platter, then layer the asparagus/pea mixture, the radishes, feta, avocado, pistachios, chickpeas, and herbs. Drizzle with remaining dressing, season to taste with more salt and pepper, and serve.
Source: www.loveandlemons.com/spring-salad/
Radish Salad with Radish Top Pesto

Serves 4 – 6
1 1/2 cups cooked navy beans, drained and rinsed
1/4 cup Lemon Vinaigrette
9 roasted radishes, halved or quartered
2-3 thinly sliced red radishes
1/4 cup pine nuts
1 tablespoon capers
1/4 cup Radish Green Pesto, (or any pesto)
1/4 cup fresh mint leaves
2 tablespoons shaved pecorino or Parmesan, optional
Additional lemon juice, optional
Sea salt and freshly ground black pepper
1. In a medium bowl, toss the beans with 2 tablespoons of the Lemon Vinaigrette.
2. Assemble the salad on a platter with the beans, roasted radishes, sliced raw radishes, pine nuts, capers, and dollops of pesto.
3. Drizzle with remaining dressing and top with fresh mint and pecorino, if using. Season to taste with more salt and pepper and extra squeezes of lemon, if desired.
Source: www.loveandlemons.com/radish-salad/
Sugar Snap Pea Salad


Serves 6
1/2 cup extra-virgin olive oil

1/4 cup Chardonnay vinegar or other white wine vinegar
2 teaspoons grated lemon zest plus 2 tablespoons fresh lemon juice
2 teaspoons minced shallot
1 teaspoon honey
1 pound fresh sugar snap peas (about 7 cups)
3 cups shredded rotisserie chicken
1 cup high-quality whole-milk ricotta cheese
1/2 cup thinly sliced red onion, rinsed in cold water and patted dry
1 cup packed fresh mint leaves
1 3/4 teaspoons kosher salt
1/2 teaspoon black pepper
1/2 cup toasted sliced almonds
1. Whisk together oil, Chardonnay vinegar, lemon zest and juice, shallot, and honey in a large bowl.
2. Thinly slice snap peas lengthwise (about 4 slices each). Add snap peas, chicken, ricotta, and onion to dressing in bowl. Tear mint leaves directly into bowl. Sprinkle with salt and pepper. Stir salad until well combined. Sprinkle with almonds.
Source: www.foodandwine.com/recipes/sugar-snappea-salad
www.voicemagazineforwomen.com | April 2024 | 11

Announcing 2024 YWCA Tribute to Women Award Recipients
YWCA NETN and SWVA’s award continues the tradition of honoring women throughout the region who are dedicated and committed to positively impacting their community.
The 33 rd Annual YWCA Northeast Tennessee and Southwest Virginia Tribute to Women Awards Banquet will honor ten remarkable women at the Bristol Train Station on Thursday, April 25, 2024, at 6 p.m.
Organizations from across NETN and SWVA submitted nominations for categories that reflect the many avenues and professions women utilize to effect change: Business/Industry, Finance, Healthcare, Mission Impact, and STEAM/Education.
“Once honored, forever inspired,” said Vanessa Bennett from the Kingsport Chamber, 2023 Tribute Award Recipient and 2024 Tribute to Women committee member. “As a former recipient of the Tribute to Women, I’ve experienced firsthand the power of celebrating women. It’s not just about recognition; it’s about amplifying voices, igniting change, and paving the way for a future where every woman’s contribution is valued and celebrated.”
An independent panel of out-of-state judges made their award selections for each category based on leadership qualities, positive impact on the community, and demonstrated growth and achievement.
“All I can say is every one of these women seems outstanding!” said Cyndy Larsen of California, 2024 Tribute to Women Panel Judge. “It was hard to choose but I made myself do it and tried to focus on the YWCA’s
Mission and who would have the largest impact on the most women, children, and diversity.”
The 2024 YWCA NETN and SWVA Tribute award recipients include:
Business and Industry

Molly Luton , Chief Marketing and Communications Officer for Ballad Health, leads forty professionals that make up the marketing and communications department. A true example of empowering others, she is passionate about identifying talent in people, and then nurturing, growing, and blossoming that talent. Her leadership and experiences have led to numerous recognitions and awards, and she continues to lead by example in the countless ways she volunteers her time and expertise. Luton’s crisis communications skills developed as part of the team involved with the merger of two health systems and a lengthy, unprecedented global pandemic (that designated rural Appalachia as “ground zero” at one point). Luton’s involvement with professional organizations shows her dedication to the growth of business leaders and collective knowledge, sharing her unique experience and success stories with other leaders in the region, across the state, and nationally.
As the Town of Abingdon’s Director of Economic Development & Tourism, Tonya Triplett oversees the operation of the Abingdon Visitor Center and the Virgina Creeper Trail Welcome Center. Because of Triplett’s efforts, the Town of Abingdon has received many accolades including
12 | April 2024 | www.voicemagazineforwomen.com

a recently featured story in USA Today where Abingdon was named Top Small Town. During COVID19, Triplett assumed leadership of the tourism department alongside her economic development duties.
She joined the Washington County Va., task force managing CARES funds for Abingdon and Washington County businesses, regularly following up with them to ensure they understood steps for fund maximization. Triplett also wrote a grant that allowed locally owned restaurants to provide prepared meals to a local food bank, benefiting 19 restaurants and providing 28,055 meals. Triplett goes above and beyond in everything she does to serve those around her.
Healthcare

After dedicating 20+ years to working with adolescents and children’s specialty programs, Sherri Feathers took on the challenge of learning the new world of crisis services, and acute and criminal justice programs. As the Sr. Vice President of Specialty Services for Frontier Health, she oversees crisis programs, domestic violence and sexual assault services, residential detox and rehab services, a 988-suicide call center, and criminal justice services. Feathers has worked to educate the region on treatment options and needs of at-risk individuals while demonstrating exceptional leadership by fostering numerous partnerships within the community to address critical gaps in the mental healthcare infrastructure and social justice issues. The birth of the Recovery Navigator program, the only one of its kind in the state, highlights her commitment to developing holistic approaches to crisis intervention and recovery support, making her invaluable to the region.

Crystal Simmons serves as the Lead Registered Dental Assistant & Infection Control Supervisor for Healing Hands Health dental operations. Through Simmons’
leadership, the dental program has more than tripled in capacity, allowing the organization to treat more than 21,500 dental and dental-hygiene patients with compassionate care that is necessary and overdue. With the explosion of dental needs in the region, Simmons also played an important part in the addition of specialty operatory services required to provide dentures and partials. The task of ensuring compliance and safety requires dedication, compassion, flexibility, a complete understanding of the requirements, the following of strict procedures, problem-solving, and an unwavering ability to deal with hardships and stress. Simmons does an outstanding job juggling everything to provide professional consistency for a constantly changing operation, all while serving as a dental assistant to dentists.
STEAM/Education

Subhashini Vashisth , Group Leader, Corporate Innovation at Eastman, is responsible for delivering increased revenue and earnings growth to the company through innovation anchored to advantaged technology platforms and disciplined marketing choices. Vashisth’s welcoming personality, regional leadership roles, awards, and accomplishments, along with her expertise in science, technology, engineering, diversity, equity, and inclusion, swiftly garners respect from both peers and the community. Through her expertise and guidance, she empowers others to navigate the complexities of STEM disciplines, fostering a new generation of innovators and leaders. A chemical engineer by training, she remains passionate about women in engineering, advocating for the lingering issue of low representation by women in this field. Participating as a speaker for the 2024 Johnson City TEDx event exemplifies her selfless investment in mentorship, enriching lives, and contributing to the advancement and diversity of the STEM community.
Dr. A. Lynn Williams , Interim Dean and Professor of ETSU’s College of Clinical and Rehabilitative Health Sciences, is esteemed for creating unique educational programs for our region. She has shaped the trajectory of
www.voicemagazineforwomen.com | April 2024 | 13

speech-language pathology, championing interdisciplinary healthcare for better access and improved education programs for future clinicians. Her undeniable impact extends across local, national, and global platforms, reflected in her extensive contributions, including hundreds of presentations, research articles, and publications. In addition to Williams’ long list of achievements, it is evident that lives have been profoundly affected through her dedicated work and leadership across various organizations. Williams has a way of making others feel special. She uplifts women and serves as a mentor to other female leaders. As a natural encourager, she teaches others to advocate for themselves and provides an extra voice when they are not heard.
Finance

Laken Fritz , CFO of Ballad Health’s Kingsport, Tenn., operations, is revered for her keen ability to apply theoretical knowledge to practical scenarios. During her tenure, she has showcased a track record of implementing innovative financial strategies that have positively impacted the fiscal health of Kingsport’s market. Fritz has spearheaded initiatives that have led to a significant reduction in emergency arrival to admission times, in addition to implementing tactics resulting in the successful management of surgical and imaging volume budgets. Recognizing the need for financial mindfulness, she has also been proactive in creating opportunities to generate savings, reduce unnecessary expenses, and ensure patients in her market receive the highest quality of care possible. Her leadership is an inspiring example of how strategic financial management can drive organizational success and contribute to the broader health and welfare of the community served.
Judy Miller has been the standing Commissioner of Revenue for Norton, Va., for more than three decades. A cornerstone in Wise County, Miller has offered tax

preparation services throughout the community, helping thousands of underserved residents, families, and businesses through her financial assistance. Recognizing the important connection between individual and community prosperity, she collaborates with multiple organizations to foster both individual socio-economic growth and community financial wellness and personally provides support to families dealing with various challenges, including utility bills, housing, and clothing needs. Her dedication and initiative exemplify the transformative power of commitment. Despite intending to retire, overwhelming community support during the last election persuaded her to continue for another term. Elected through a rare write-in process, she’s affectionately known as “Ms. City of Norton,” a testament to her profound impact and enduring legacy.
Mission Impact

As Ballad Health’s first-ever Chief Health Disparities Officer, Dr. Paula Masters is responsible for the development and implementation of many community and social health programs/services that address systemwide and regional disparities and inequities. Throughout her career, Masters has conducted extensive work in health promotion and improvement, social determinants of health, community mobilization, and rural health disparities that impact vulnerable and underserved populations. She propelled the development of tracking mechanisms and systems that allow Ballad to make well-thought investments in its Community Health Improvement site funding, which supports dozens of regional community-based organizations with millions of dollars of investments each year. Under Master’s leadership, the funding program supports specific goals and strategies aimed at improving health outcomes for diverse populations, ranging from providing social support services and navigation for women suffering from addiction to keeping youth from dropping out of school.
14 | April 2024 | www.voicemagazineforwomen.com

Promise
leads the Bristol Community Remembrance Project Coalition. These community leaders represent multiple sectors including faith, education, nonprofit, and government. After completing a 37-year career in corporate human resources, McDaniel had a vision for bringing the history and contributions of the African American community of Bristol TN/VA to light, recognizing that this history was largely absent from the local historical landscape. She has and continues to put much time and energy into multiple projects, researching extensively for historical accuracy. McDaniel serves on multiple boards across the region and is very active in the community, including having pivotal roles in Bristol’s MLK Jr. and Juneteenth celebrations. Her involvement attests to McDaniel’s invaluable contributions as a leader, a generator of ideas and a worker who has a servant’s heart.
Bristol Train Station is located at 101 Martin Luther King Blvd., Bristol, Va. Tickets can be purchased online at www.ywcatnva.org/tribute-to-women-tickets/. Funds from this event support the mission of YWCA Northeast Tennessee and Southwest Virginia including efforts to eliminate racism, increase the economic empowerment of women and girls, and promote women’s health and safety. YWCA NETN and SWVA is proudly celebrating 80 years of serving and empowering those within the community.



www.voicemagazineforwomen.com | April 2024 | 15
Tina McDaniel , Diversity, Equity, and Inclusion Program Coordinator for Appalachian
Alliance
Barter’s Black Stories Black Voices Initiative Shines Light on Stories from Appalachia
By Serina Marshall
When one thinks of Appalachia, a few images come to mind — foggy mountain ranges, coal mining, and bluegrass music being just a few. However, Appalachia is so much more than the stereotypical collection of mental slideshows one may click through.

The stories of Black Appalachian experiences are an important example of history that has been overshadowed and underappreciated in its mark on building history. Black Appalachians’ stories are rooted in history that runs deeper than the mountains themselves and have become a canon for stages from foothills to footlights. These stories have been collected and handed down through generations, important memories, and experiences that have shaped the lives

of Black Appalachians. They are stories of hardship and hope, told by the voices that echo their legacy.
Black Stories Black Voices (BSBV) was created in 2020 after the death of George Floyd, a headline that shook the nation to its core. According to Terrance Jackson, Director of Outreach and Black Stories Black Voices at Barter Theatre, Barter knew they had to respond and face the reality that the stories of the Black community and especially the Black Appalachian communities were not being represented in a way that best represents the values of our theater and our leadership.

“It started as a playwriting addition, where we committed to reading one new play by a Black playwright in Barter’s annual Appalachian Festival of Plays and Playwrights. It has since grown into a mission to tell and amplify Black stories and Black voices through playwriting, acting, and all theatrical disciplines,” Jackson said. “With BSBV, we hope to help shine a light on the richness of the Black experience in the
16 | April 2024 | www.voicemagazineforwomen.com
Rita Cole, Shine 2023 (Image courtesy of Barter Theatre)
Kelle Jolly, Shine 2023
(Image courtesy of Barter Theatre)
Appalachian region, and for this region, with plays, readings, and community engagement opportunities such as our post-show events during our main stage season and our annual monologue event called SHINE: Illuminating Black Stories.”
BSBV collects stories from Black community members throughout Appalachia and from news articles, and or books.
“With permission from the original owners of those stories, we give Black Playwrights from all over the world the opportunity to write about those original stories—giving voice to unheard people, places, and events,” Jackson explained.
Following the ideals set forth by Barter founder Robert Porterfield concerning inclusivity, BSBV provides opportunities for Black stories and artists to have a place on Barter’s stages. By upholding the idea that all of Appalachia should have a place to see themselves onstage, BSBV is changing the face of what it means to be a playwright in Appalachia.

Our hope is that Black people in our region see Barter as a place that sees them for who they are and welcomes them.
— Terrance Jackson
“I hope (BSBV) means that people in our region care about diverse stories, storytelling, and storytellers, that the Black stories from our region matter and have a place on all stages, and that they should be told,” Jackson added. “Our hope is that Black people in our region see Barter as a place that sees them for who they are and welcomes them.”
Not only does BSBV support representation for all of Appalachia, but it also enriches the community on a multicultural level — a bigger stage than even Jackson could have imagined.
“BSBV provides opportunities for our community to support Black theatre, stories, and artists. It enriches the community by giving them theatrical programming that they may have never seen before and don’t have access to unless they went to a larger city,” he said. “It enriches the community by educating our
audiences on Black histories that come from this region, and it also exposes our audiences to the Black American Theatre canon, when we produce such plays like SKELETON CREW by Dominique Morisseau or HOME by SammArt Williams.”
Having this kind of representation is also a very important part of, not only theatre but the history of the region and those that have experienced it.
“If we don’t have representation, how will the next generation know they can do something?” Jackson emphasized. “I hope through BSBV we are showing young Black people that they can be a theatre artist when they grow up and have a career. I hope we are showing other regions that they can tell the Black stories of their regions also, and that people will come and will want to support.”
Ultimately, according to Jackson, it’s important for us to expose our audiences to the Black American Theatre Canon while also creating the Black Appalachian Theatre canon.
“We’re a young program and initiative compared to the rest of the Barter company as a whole, but we have a strong vision for the expansion of this programming, and I’m excited to see what the future will hold for BSBV,” he said.
For more information on BSBV please visit https://bartertheatre.com/black-stories-black-voices/.
www.voicemagazineforwomen.com | April 2024 | 17
Terrance Jackson, Shine 2023 (Image courtesy of Barter Theatre)
NEW RELEASES OUT NOW!









































The Very Contrary Fairy
Written by Julia Hurley
Illustrated by
Jessica Beaver
The very contrary fairy sure has a lot to say about what she must do each day. But when she decides to run away, will she make it home in time and stay?
Online readers: click here to order.
Boundaries.
Written
by Justin Shepherd
Meet Victoria, a curious little girl who wonders why she gets to see her mom’s family but not her dad’s. In Boundaries., Justin Shepherd skillfully tackles the delicate topic of family dynamics and the importance of setting boundaries in a way that children can understand. With charming illustrations and a gentle tone, Boundaries. is a must-read for children and families alike. It encourages open conversations about family relationships, respect, and the importance of safeguarding our emotional well-being.
Jan-Carol Publishing, Inc. is a small independent publishing press with a motivated force of authors. Mountain Girl Press, Little Creek Books, Express Editions, DigiStyle, Broken Crow Ridge, Fiery Night, Skippy Creek, and RoseHeart Publishing are all imprints of Jan-Carol Publishing, Inc.


Steamy Creek A Cozy Romance Anthology
Written by Various Authors


Online readers: click here to order.


Sad Eyes: Book Two
1939 to 1951
Written
by Dan Perkins
Sad Eyes: 1939 To 1951 is the story of a blossoming woman, Mary Ellen Murphy, from Waterloo, Iowa. She finds herself stationed at Hickman Hospital in early December 1941, and she’s halfway through her honeymoon when the Japanese bomb the fleet in the harbor. She is the right person, in the right place, at the right time to significantly contribute to the war effort. As an Army nurse over the balance of World War II, Mary Ellen helps save tens of thousands of soldiers’ lives. Her assistance to Army Chief of Staff John Marshall throughout her journey proves crucial to the war’s outcome. Join this red-haired, green-eyed, Irish lass who is as intelligent as she is beautiful on her adventure during World War II and its aftermath.
Online readers: click here to order.



Remembrances II
Written by Charles H. Norman III





























This book is a collection of 32 true-to-life anecdotal short stories about intriguing people author Charles H. Norman has known, special places he’s traveled, and providential experiences that has come his way. Charlie writes as he talks, so as to connect with the reader quickly and easily. The goal of Remembrances II is to give the reader a respite from the hectic world in which we live …
all the while entertaining, inspiring, and challenging readers to count each day as a gift from the One who made us. Online readers: click here to order.






Stories for the hopeless romantic! Take a dip in Steamy Creek where you’ll find flirtatious characters and tender tales of love. Seven talented authors come together to create an irresistible anthology that will leave you feeling smitten with every page. Online readers: click here to order.
The Mitchellgoshes: Party in the Wishing Well (Book 2)
Written by Retta West
Illustrated by Grayson Campbell
The Mitchellgoshes are back. They are getting ready for their biggest adventure yet, and yes, our sweet friend the pink pig is back with new friends of her own. Can’t wait. See ya soon. Online readers: click here to order.
The Green Knight: A Fairy Tale & A True Story (Coming Soon)
Written by Anna L. Sobol
Illustrated by Blake Marsee
Candisi Avita loves being a Green Knight. But when she must choose a different path, she finds a new adventure that changes her life forever. Online readers: click here to pre-order.
Abamo’s Gift (Coming Soon)
Written by Donald Greco
Abramo’s Gift is a family saga and love story that takes place in Youngstown, Ohio, in 1920. A disheartened, young, Italian widower, an immigrant named Abramo Cardone, arrives in Youngstown to work in one of the steel mills there. At the time, the small city seethed with ethnic strife between Italian and Irish immigrants because they were forced to underbid each other for low-paying jobs in the mills. Amid this turmoil, Abramo saves the life of an Irish girl who has been raped by two members of a vicious local Irish gang called the Hannons. Abramo is also injured in the rescue, and his life is saved, in turn, by a little orphaned street urchin who hides him from the same gang. All the people in Abramo’s life interact in this story to unite him, the Irish girl, and the little girl who saved his life. It is a multifaceted love story. Online readers: click here to pre-order.
18 | April 2024 | www.voicemagazineforwomen.com Jan-Carol Publishing Books www.Jancarolpublishing.com www.Amazon.com www.Barnesandnoble.com
every story needs a book
sure has a lot to say do each day. to run away, time and stay? wonders why she gets to see her Justin Shepherd skillfully dynamics and the importance of setting understand. decision—no contact with certain family the sake of our well-being and mental from people who aren’t good for us. understanding as her parents help her navigate Through their guidance, she learns healthy boundaries are the keys to tone, Boundaries. is a must-read for encourages open conversations about family importance of safeguarding our emotional complexities of family and boundaries with understanding, and easily consumed by kids and adults. practice as therapist, and with my own to set boundaries is crucial part of written book that dismantles the idea our lives, just because we’re related.” anecdotal short stories about Norman has known, special that has come his way. the reader quickly and reader a respite from the entertaining, inspiring, and the One who made us. stories since his days as editor of late 1960s. That interest lay to be a regular guest colum paper. His articles were so well them (and other stories he’d book, Remembrances II is the wife Carolyn have two adult make their home in the Remembrances II Charles H. Norman III Wri b Retta West The Mitchellgoshes are back. They are getting ready for their biggest adventure yet, and yes, our sweet friend the pink pig is back with new friends of her own. Can’t wait. See ya soon. Party in the Wishing Well Illu ed Grayson Campbell Book 2 ELOUISE H., reader from Ft. Myers, Florida children’s and adult books. He TV talk show host, current philanthropist. Dan and his wife Gerri parents of four wonderful sons grandchildren. Visit him at woman, Mary Ellen Murphy, Hickman Hospital in early honeymoon when the Japanese right time to significantly balance of World War II, lives. Her assistance to Army proves crucial to the war’s with incredible talent and She is constantly being and prove to others what red-haired, green-eyed, Irish lass during World War II and BOOK TWO 1939 TO 1951 SAD EYES BOOK TWO • 1939 TO 1951 DAN PERKINS Anthology COVER PHOTO: CLEVERSTOCK/ADOBE STOCK Steamy Creek Stories for the hopeless romantic! Take a dip in Steamy Creek where you’ll nd irtatious characters and tender tales of love. Seven talented authors come together to create an irresistible anthology that will leave you feeling smitten with every page. Featuring Authors: A Cozy Romance Anthology Candisi Avita loves being a Green Knight. But when she must choose a different path, she finds a new adventure that changes her life forever. The Green Knight A Fairy Tale & A True Story The Green Knight bramo’s Gift is a family saga and love story that takes place in Youngstown, Ohio, in 1920. A disheartened, young, Italian widower, an immigrant named Abramo Cardone, arrives in Youngstown to work in one of the steel mills there. At the time, the small city seethed with ethnic strife between Italian and Irish immigrants because they were forced to underbid each other for low-paying jobs in the mills. Amid this turmoil, Abramo saves the life of an Irish girl who has been raped by two members of a vicious local Irish gang called the Hannons. Abramo is also injured in the rescue, and his life is saved, in turn, by a little orphaned street urchin who hides him from the same gang. All the people in Abramo's life interact in this story to unite him, the Irish girl, and the little girl who saved his life. It is a multifaceted love story. “Donald Greco leads the reader to the early 20th century, where all people in the United States fought for survival no matter their culture. There were clashes and love that crossed the lines of our forefathers. This is a wonderful telling of the many hardships that were experienced during that time.” — L H H A Abramo’s Gift DONALD GRECO
Now Accepting Your Horror Short Story Submissions
Jan-Carol Publishing, Inc., of Johnson City, Tennessee, is now accepting submissions for the sixth edition of These Haunted Hills: A Collection of Short Stories.
Jan-Carol Publishing’s These Haunted Hills series has produced five frightening editions since debuting in the fall of 2017. Each anthology is filled with stories that indulge readers’ curiosity for the supernatural from an array of accomplished authors. These Haunted Hills: Book 6 is set for publication in autumn 2024.
Stories submitted to the sixth edition of JCP’s haunting anthology collection should follow the theme of spooky or supernatural stories set in the Appalachian region. Stories must be fiction. Please include with your submission a short author bio. Author bios should be no more than 50 words and should be written in the third person.
have a minimum of 1500 words and a maximum of 3500 words per story.
Authors accepted to the anthology will receive two free books upon publication. The deadline for submissions is May 31, 2024. Send your submissions to submissions@jancarolpublishing.com. Join the host of talented writers to take part in our most beloved anthology series!

Other Jan-Carol Publishing Appalachian-themed anthologies include their spring collection, consisting of Daffodil Dreams; Scattered Flowers; Wild Daisies; Easter Lilies; and Broken Petals. In addition, the company has also released a winter anthology, Snowy Trails: A Collection of Short Stories, and a romance anthology, Steamy Creek: A Cozy Romance Anthology. Each book is an assortment of stories from talented and award-winning authors, many of whom are recurring contributors across Jan-Carol Publishing’s anthology collections.
The submission fee per story is $20, and authors are allowed to submit a max of two stories. You may call the office at 423.926.9983 with a credit card number or mail a check to JCP at P.O. Box 701, Johnson City, TN, 37605. Stories must
Raven Howell
Author of Seasons
AUTHORS on the ROAD
Appalachian Authors Guild
The AAG meeting for Tuesday, April 9, will be held from 1–3 p.m. at the Virginia Highlands Small Business Incubator in the large conference room. This will be our READ forum. If you want your work to be read and talked about, your entry needs to be emailed to Vicki Fletcher at vfletcher56@gmail.com by April 1st (no fooling). This is to allow the “judges” time to read your entries and have their comments ready to share with you. You can attend in person or via Zoom so please consider sending in your entries. This has become a favorite meeting in the past couple of years. Please also let Vicki know if you will attend in person or via Zoom by April 1st so plans can be made to allow time for all entries to be read and commented on. The Board Meeting will take place from 12 p.m. to 1 p.m. before the READ Program.
Jan-Carol Publishing, Inc. includes various imprints, each specializing in a particular genre—from Appalachian stories to children’s books and more. At JCP, we believe ‘every story needs a book.’ For more information or to schedule a book signing, call Jan-Carol Publishing, Inc., at 423.926.9983, or visit jancarolpublishing.com. Follow JCP on Facebook.
Sunday, April 14, 2 p.m. – 4 p.m.
Newburgh Free Library Fair
124 Grand St., Newburgh, NY 12550
Jessica Brimer
Author of A Binding Chance; Book High and Low; These Haunted Hills: A Collection of Short Stories Book 5
Saturday, April 27
Book Signing
Maple Tree Book Shop & Coffee House 101 E Jackson St #10 Gate City, VA
Rebecca Williams Spindler
Author of Easter Lilies; Daffodil Dreams; Sara Jane is a Pain; Life According to Liz; Moving Out and Moving On Wednesday, April 10
Faith Forward Writers Retreat
Sparrow’s Nest 27304 Havenwood Rd., Sparta, WI
Linda Hudson Hoagland
Author of The Lindsay Harris Murder Mystery
Series, The Best Darn Secret; and anthologies
Easter Lilies; Broken Petals; Wild Daisies; Scattered Flowers; Daffodil Dreams; and These Haunted Hills: A Collection of Short Stories
Books 1-5. Weather Permitting:
Friday, April 5, 10 a.m. – 4 p.m.
Book Signing at Food City, Wise, VA
Saturday, April 6, 10 a.m. – 4 p.m.
Book Signing at Food City, Claypool Hill, VA
Tuesday, April 9, 12 p.m. – 3 p.m.
Appalachian Authors Guild Board Meeting 12 p.m. – 1 p.m.
Workshop “READ FORUM” 1 p.m. – 3 p.m.
Virginia Highlands Small Business Incubator Abingdon, VA
Friday, April 12, 10 a.m. – 4 p.m.
Book Signing at Food City, Bluefield, VA
Saturday, April 13, 10 a.m. – 4 p.m.
Book Signing at Food City 2120 S. Roan St, Johnson City, TN
Friday, April 19, 10 a.m. – 4 p.m.
Book Signing at Food City, Pikeville, KY
Saturday, April 20, 10 a.m. – 4 p.m.
Book Signing at Food City, Radford, VA
Friday, April 26, 10 a.m. – 4 p.m.
Book Signing at Food City Clinchfield, Kingsport, TN
Saturday, April 27, 10 a.m. – 4 p.m.
Book Signing at Food City, Gray, TN
www.voicemagazineforwomen.com | April 2024 | 19 every story needs a book


Over the Circumstances is a book of engaging, relatable, true stories and observations about life that help the reader to learn biblical truths through human experiences. The author shares insights the Holy Spirit has opened to her as she observes the lessons that God has hidden in His creation and the everyday, mundane occurrences of life.



Jan Ellis Doreen J. Oberg Jenn Sadai Connie Clark-Thompson
Author Oberg opens the doors to anyone who has ever questioned aspects of their upbringing. The reader will find that Mile Markers is literally one question after another from different points in the author’s life. The reader will share her experiences and her desire to “learn beyond” and walk forward towards unexpected horizons. If you have ever questioned family ties rooted in religious teaching, this book is for you.

No Kids Required is the story of 20 women who are choosing to be child-free. It showcases the blessings and burdens that come with their decision, how they fill their free time, and the countless reasons why these women decided that kids are not required. It’s an honest and insightful story about respecting one another’s choices and living life on your terms.
The poverty of our senses both physical and spiritual is in ourselves not our surroundings. No matter where you call home, the heavens by night or day are as beautiful over your home as another. The lifestyle that we become immersed in decay our senses and cheat us of many treasures beyond price. The author takes the reader into the love of nature and God’s Word and showing there are always new discoveries on every path. The reader will be immersed in their senses being delighted or sharpened.
Nancy Withington Bell
Author Nancy Withington Bell shares rich authentic stories from 24 women who bravely made a move to a new region. In the mountain hollows of Tennessee, the newly arrived “girls”—young, suburban women from 15 states—supported each other, learning country ways and how to produce their own water, warmth, and food. Fleeing urban consumer culture and the social strife of the 1970s, they learned from the locals, became strong women, and formed a lasting community.
Order this book directly from JCP — for a discounted price and FREE shipping in April! Go to the “JCP Book Shop” at www.jancarolpublishing.com.
20 | April 2024 | www.voicemagazineforwomen.com
Publishing Books
on the cover to purchase
www.Jancarolpublishing.com
www.Amazon.com
www.Barnesandnoble.com
Jan-Carol
Click
•
•
•
It’s April; that means it’s National Pet Month! United in love for our furry or scaly friends, we celebrate. Check out these books on different kinds of animals that we love!

Olivia Carmichael
Is Walter the only orange fish in the whole ocean? Join Walter on his journey across the sea as he looks for a place to belong.

Books You May Have Missed!



Hunter D. Darden
Gorgeous Georgia: A Story of Inner Beauty is about a giraffe who brags on herself to the other animals, calling herself Gorgeous Georgia. She eventually learns that beauty comes from within your heart. The other animals learn that you should never judge others because you don’t know what they are dealing with.
Dennis W. Brown
The author recounts an event with the family as a child in Oklahoma and creates an adventurous journey for the reader. A family looks for a place to live and they find a fix-it farm. The mother, father, and a young boy find a place on a goat farm and it becomes an adventure with the goats as the goats try to burn down the world.
Katie Meade
Chucky Mouse and his family move into the attic of candy maker Mrs. Shelton, but Chucky’s love for chocolate gets him into real trouble. Disobeying his mother, Chucky visits the kitchen alone at night. Giant pools of chocolate and a hungry cat confront Chucky as he makes his escape. Run, Chucky, Run!
Order these books from our JCP website (Jancarolpublishing.com) for free shipping! Click on the cover to purchase or go to “JCP Book Store” at the top of our homepage!
Jan-Carol Publishing Books
www.Jancarolpublishing.com
• www.Amazon.com •
www.Barnesandnoble.com
Yesterday’s Books and Tomorrow’s Reading
www.voicemagazineforwomen.com | April 2024 | 21
Morrison School Field Trip to Meet the JCP Team
By Allison Chudina
Have you ever wondered about what goes on behind the scenes of a publishing company? Several high school students from Morrison School in Bristol, Va., recently learned first-hand when they visited Jan-Carol Publishing’s office and bookstore for a special field trip.
On March 21, the 17 students and three teachers toured JCP’s offices and met with the JCP Team.
Students were introduced to each JCP team member and learned about the various job duties of each, starting with Allison Chudina, who talked about editing and writing; then moving on to Tara Sizemore to learn about graphic design; and finally, to Draco Bailey to learn about marketing. Janie C. Jessee guided the tour while also informing students about the publishing process as a whole.
The tour concluded with an open Q&A, during which the high schoolers were encouraged to ask questions about what they just learned. Students also took home a goody bag and one free book of their choice.
“It was so wonderful to see students’ faces light up as we went through the tour,” Jessee said. “The students came with questions and enthusiasm, and JCP is so honored to have been a part of this event. Hopefully, we helped encourage a lifelong love of and interest in reading and publishing.”






22 | April 2024 | www.voicemagazineforwomen.com Turn your idea into a book! Let’s work together to finally get that book on paper, in your voice! PROFESSIONAL GHOSTWRITING SERVICE GET A QUOTE! Call: 276.979.9373 Email: lhhoagland@gmail.com
Publishing, Inc.
to
Jan-Carol Publishing, a small book press, brings book publishing tips, changes in the book publishing industry, introduction to authors, books, and working behind the scenes in the book publishing industry. Listen, learn, and enjoy the interviews with different authors.
Jan-Carol
Listen
our new podcast!
5 Common Mental Health Conditions
Mental health disorders are more common than one may think. Despite dramatic strides in reducing the stigma surrounding mental health, there are some who remain hesitant to bring up mental health issues. However, the World Health Organization says one out of every eight people around the world lives with a mental disorder. Considering there are nearly eight billion people in the world, that equates to one billion with a mental health condition. Mental disorders affect thinking, feeling, mood, and behavior. Some mental health conditions can be chronic, while others are temporary, indicates MedlinePlus. Mental illness can result from life experiences, traumatic brain injury, genes, family history, and other biological factors. The following are some of the common mental health conditions people may experience.
1. Anxiety disorders — Anxiety disorders are a group of conditions, including generalized anxiety disorder, social phobias, specific phobias, panic disorders, obsessive compulsive disorder, and post-traumatic stress disorder. These conditions are characterized by feelings of worry, fear, and nervousness that are strong enough to interfere with daily activities.
2. Depression Depression involves feeling sad, irritable, or empty. Loss of pleasure or interest in activities, including ones that were once enjoyed, can occur. These feelings need to occur every day, for most of the day for at least two weeks to be classified as depression, says the WHO. People with depression often feel hopeless about the future, may have changes in sleeping patterns, may have changes in appetite, and may feature low energy.
3. Eating disorders — WebMD indicates eating disorders involve extreme emotions, attitudes, and behaviors involving weight, body image, and food. Anorexia nervosa, bulimia nervosa, and binge eating disorder are the most common eating disorders. Body dysmorphic disorder also is a mental health condition, and it involves worry about flaws in appearance, which can be related to eating disorders.
4. Addiction and impulse control disorders — Individuals with impulse control and addiction disorders are

unable to resist the urges to perform acts that can be harmful to themselves or others. These behaviors can include using drugs or alcohol, gambling, sexual addictions, kleptomania, and others.
5. Bipolar affective disorder — This is a type of mood disorder previously known as “manic depression.” Someone with this condition experiences episodes of mania (elation) and depression, says Better Health Victoria, an Australian health resource.
Speaking with a doctor about mental health conditions is the first step to getting help. There are many different treatment options, including cognitive behavioral therapy, counseling, medication, meditation, and other options.


www.voicemagazineforwomen.com | April 2024 | 23 Wide Table • Home Visit Option Schedule today! 423.481.9012 MeritMassageCare.com Soothing | Therapeutic Pain Easing | Anxiety Reducing Sleep Improving | Comfor ting Bring in this ad for $15 O a Session!
Effects of Laughter on the Aging
By Cindy K. Sproles
Laughter is healing. Medical professionals have proven through studies that laughter increases specific endorphins in the brain that aid in the healing process. According to a study done by Farkhondeh Sharif and colleagues listed in the National Library of Medicine in 2015, “Laughter causes synchronized contraction of facial muscles, increases respiratory rate, blood flow and the release of adrenaline in the blood and ultimately leads to joy and happiness. It is the cheapest medicine for preventing many diseases and fighting against them.”


In a similar study by a medical team at the University of Maryland School of Medicine, Dr. Michael Miller discovered that laughter is linked to healthy function in blood vessels.
“The old saying that ‘laughter is the best medicine’ definitely appears to be true when protecting your heart,” says Dr. Miller. (University of Maryland School of Medicine, 2009).
Laughter releases stress, improves the mind and attitude, and helps us look at life more positively. Not only is it important to us, but laughter is a vital aspect for our aging parents.
Mary Maxey, an elderly woman, was asked to offer a prayer at a national caregivers convention. She stood at the podium, face blank and somewhat frustrated to be a presenter. “Over the years, I’ve noticed that the two things people want to know about you are the two things they’re far too polite to ask. So let’s get these out of the way.” A hush fell over the crowd. “I’m 72 years-old.”
Laughter erupted across the room, and when the crowd quieted, she continued. “And I weigh 145 lbs.” In these two brief sentences, this senior woman not only made others laugh but also smiled at her situation.
Finding the humor in life defuses the hard situations. Laughter allows us to relax, take a breath and refocus. It improves moods, helps ease pain, lowers blood pressure, reduces stress, increases muscle relaxation, and decreases anxiety and fear. Laughter causes us to take in additional oxygen, which revitalizes the blood and feeds and refreshes the brain, leaving us with a sense of well-being.
Aging seniors will admit that fear often replaces the laughter of their youth. The clumsy trips that once brought a chuckle in their younger years now appear as serious hazards. The fear of being left alone or forgotten seeps into their lives, pushing away the joyful memories of their past. The reality of loss-of-function tears away their self-confidence, leading to depression and hopelessness.
Encourage your elders to recount the joyful antics of their youth and tell the stories that made them laugh. Involve them in activities that evoke happiness and surround them with the laughter of children.
Many hospitals and long-term healthcare facilities prescribe laughter therapy for their patients on television with comedy channels and humorous movies. They encourage clowns, humorous storytellers, and pet therapy - all things that restore joy and laughter.
Include seniors in family time, where they can share fun stories, jokes, and movies. The effort will help restore a missing element in a senior’s life and build a tight family bond filled with wonderful memories.
Sometimes, our seniors are not always loveable through the bumps of aging, but it’s important to remember why they are the way they are. Growing old is new territory for them, and it’s not something they’re allowed to practice ahead of time. Helping to restore the laughter and joy of their youth will revive a part of our seniors that may seem to have been lost.
Laugh with your aging parents. The effects are life-changing.
Cindy K. Sproles is a novelist, speaker, and conference teacher. She is the cofounder of ChristianDevotions.us and the managing editor for Straight Street Books and SonRise Devotionals, imprints of Lighthouse Publishing of the Carolinas. Visit Cindy at www.cindysproles.com.
24 | April 2024 | www.voicemagazineforwomen.com
{
Voicemail Male
 By Ken Heath
By Ken Heath
Walking Home
Those of us of a certain age remember the metal trays stacked behind the kitchen door that were a circus balancing act, the tin foil topper that emitted a stream of steam that would scald your eyebrows off your head, the pea-and-carrot juice that always ended up flavoring the dessert—no matter how careful you were. TV dinners. They were a splurge for us, so when we got ’em we dared not complain about any of the above. But looking back, that salty brine water that swirled into the cherry cobbler adjusted my taste buds so that, as a grizzled old coot, I love to experiment with flavors. Now, I’ll admit I’m not brave enough to do the veg/dessert blend, but I do love cooking from scratch, blending foods that I enjoy with other, similar vittles, and creating stuff that sometimes amazes me, sometimes scares me, and often ends up making me search the freezer in case there’s a leftover Hungry Man Salisbury Steak frozen dinner stuffed underneath the icy blocks.
As I’ve aged, foods that were disgusting to me as a kid now are favored—bleu cheese, sriracha, ramen noodles with Szechuan crisp, hot honey, and even flashbacks to my fishing days with my grandad on trout opening day as I snarf down a can of “minners and sody crackers” as he called them. I’ll still champion sliced corned beef and hoop cheese on light bread with mayo, mustard, a thick slice of onion, a pack of peanut butter nabs, and a Penrose sausage, or a heated-up can of Chef Boyardee ravioli with a Sprite (my go-to meal on a sick day). I’ll broil and scrape out beef bone marrow on a crusty bread, gobble up oysters any way you can serve them, like my t-bone well done but my prime rib almost ready to let the vet check it out—just add a bit of au jus and a healthy dollop of horseradish.
My whole life, I feel I’ve defined it as a food journey. Firehouse ribs. Miss Lisa Canty’s fried chicken. Mark’s magical collards and smoked BBQ at Eatz. Dip Dogs. Kingburger slaw. Gus’s prized yardbird in the heart of Memphis. Gumbo and muffulettas in Nola. Demos’s steak and spaghetti in Nashville. Havana ’59 and CHETTI’S Cow and Clam and Mama Zu’s
in Richmond. Dairyland and Biff Burger and Mr. Miller’s chicken. A flavor-filled kaleidoscope of tastes that shaped me, figuratively and literally.
Now, I’m still enjoying all my foods, but in moderation. That’s what I’ve always struggled with. It’s like eating Thanksgiving dinner—full as a tick and then the pumpkin pie comes out. But for me, it was EVERY meal. I’d eat ’til I was full. Then eat ’til the plate was clean. Then eat ’til it was gone. We didn’t waste food, I was taught, and I believed every word of it.
I still find myself scooping more than I actually can put away and regretting it now that I’ve developed a hard cut-off switch, thanks to modern medicine. At 61, I’m relearning how to portion, and that it’s okay to snack, but to grab that pear instead of pie or a pack of my noodles instead of a handful of candy.
I find myself struggling to fit into my clothes but in a far different way than ever before. My drawers droop to the point of dropping, so I’m cinching up my belt like Jethro. I catch glimpses of myself in the mirror and am startled a bit. I’ve had slacks altered to fit, but when I went to put them on, my mind told me they were way too small. But ya know, they fit like a glove!
I pray every morning and every night for God to continue to guide me on this journey for real and lasting health. He’s blessed me, carried me through perilous valleys, and now, He’s seen fit to keep me around after my battles with Covid, A-Fib, broken fingers, a shot hip, two bum knees, and a grumpy disposition.
I’ve got fifty pounds to go, then I’m in shooting range for a hip replacement. If that’s to be, I’ll be able to be mobile and active again and I’m so ready. I know it sounds selfish, and I suppose it is. But I want to be able to dance again with my Angel, walk my dogs, not hesitate for a date night, not wonder if the chairs will have arms that will limit my ability to sit down, be sturdy enough to hold me, to be close enough to a sturdy support to allow me to push up when we’re ready to leave.
We’ll get there. I’m confident. And I’m bearing it all with you, my friends, because I know everyone has their struggles. If my journey can help you, it’s all worth it.
As my buddy Greg Vannoy, who struggled with me on his weight, used to say, “We’re all just walking each other home.” Greg lost his fight last month and gained his wings. He’s walking again, in his heavenly home. And, with God’s Grace, I’ll walk just as effortlessly here on earth again before I join him home.
Whatever your struggle, know that we’re all going through stuff too—and we’re here to walk each other home.
Take my hand and come along.
www.voicemagazineforwomen.com | April 2024 | 25
Ken Heath is a Marion, VA hometown boy who expresses his passions in his writings and through music. After his ‘real job’, Ken is owner of the legendary Cliffside Roadhouse, doggie dad to Miss Reagan and their rescue Scottie the Wonder Dog with his wonderful wife. Follow him on Facebook and on Twitter at #kenheath.
{

The Last Supper
By Kelly McFadden
When Jesus had thus said, he was troubled in spirit, and testified, and said, “Verily, verily, I say unto you, that one of you shall betray me” Then the disciples looked one on another, doubting of whom he spak. — John 13:21-22 KJV
Interpretation: After he had said this, Jesus was troubled in spirit and testified, “I tell you the truth, one of you is going to betray me.” His disciples stared at one another, at a loss to know which of them he meant.” – John 13:21–22
Ioncehad the opportunity to view the famous painting, The Last Supper, by Leonardo da Vinci in person. Having seen pictures and copies of the painting over the years, I never quite understood what all the hype was about. After taking a twenty-minute tour of viewing the original and having the painting explained to me, I must admit, I have a far greater appreciation for this work of art.
The well known da Vinci finished painting The Last Supper in 1498 on the wall of the rectory of the Santa Maria delle Grazie in Milan, Italy. Our tour guide explained that this portrait represents the reactions each
The Potential Health Benefits of PLAYING PICKLEBALL
It’s National Pickleball Month! Anyone who lives in close proximity to a pickleball court can no doubt attest to the popularity of the sport. The thrill of competition and the joy of social interaction undoubtedly have contributed to the popularity of pickleball, but those are not the only benefits to participating in this fast-growing sport. Indeed,


of the disciples had at the moment Jesus told them that one of them would betray Him. The guide explained, moving from left to right, that the first three are surprised by the news, Andrew even holds his hands up as if to say, “Not me!”
The next group of three is Judas Iscariot, Peter, and John. Judas holds in his hands a small bag of silver, the money given to him as payment to betray Jesus. Peter holds a knife in his hand, a foreshadowing of what will come later in the garden. Philip is among the next group of three to the right of Jesus. Those with him seem to be stunned and Philip is pointing at himself as if asking, “Could it be me?” The last three seem to be in discussion as if attempting to decipher who the betrayer is.
As this painting was being explained, I couldn’t help thinking which reaction I may have had that evening. If I had been sitting at the table with Jesus, would I have wanted to spring into action and defend the Lord? Would I have questioned my own loyalty? Or would I have been somewhere in between shock, denial, or defiance? Staring at the painting, I found myself praying that the Lord would continue to strengthen my faith.

•
Stop
•
there are many potential health benefits to pickleball as well.
• Pickleball provides a fun way to embrace physical activity.
• Pickleball provides social benefits that positively affect longterm health.

• Pickleball can lead to a healthier heart.
• Pickleball can benefit brain health.
A 2023 study published in the journal Frontiers in Psychology found that pickleball participation led to significant improvements in personal well-being, life satisfaction, and happiness.
On His last evening before the crucifixion, Jesus broke bread with His closest friends, one of whom later betrayed him and another, Peter, who would deny Him three times. Yet, Jesus loved each one of them, even though He knew what would happen and how they would hurt Him. An important reminder today is that He loves you in the same way, unconditionally. He simply asks that you be like Peter, admitting your shortcomings and never letting go of your faith and love for Him. www.homeword.com 791
26 | April 2024 | www.voicemagazineforwomen.com
Old Gray Station Rd • Gray, TN 423.477.7146 • lifecarecenterofgraytn.com
by today f a tour!
are a perfect choice for:
Rehabilitation
We
• Short-Term
Long-Term Care
Post-Operative Recovery
Care Center of Gray focuses on inpatient and outpatient rehabilitation with 24-hour skilled nursing care.
Care Center of Gray
Life
Life
HA Season of Renewal
By Raven Howell

ow often have you experienced a baby, however gently, taken from a snug space in Mommy’s arms move into a fit of cries? Change to the unknown, a letting go if even for a minute or two, can be frightening for them.
A toddler has a screaming fit when her parent leaves for work in the morning. Separation anxiety is normal and happens as children begin to differentiate between things that are safe and familiar and things that are new and different.
Fast forward, oh, say 95 years or so. My mother-in-law chose her passing wanting to be at home, with family and hospice care surrounding her. It’s her turn to leave now, and we adults, are struggling with a similar reaction — involving separation, letting go, change. It’s part of life’s cycle but knowing that doesn’t necessarily make it less stressful.
My picture book, Seasons , illustrates the ebb and flow of months going by, and the cyclical nature of nature, from new grass and baby rabbits to green leaves turning colors and dropping, leaving the earth bare. It’s a profound connection to our lives, and the month of April, known for ushering in freshness and rebirth, may be a good time to reflect on the subject of release and the healing process, particularly in regard to children in your life.
The duration and intensity of grief may be different for each person and situation. Preschoolers often struggle to understand what the death of a loved one means. If your child expresses some regressive reactions like bed wetting, they’re trying to cope with the change and emotions the loss is triggering.
An older child might burst out in sudden grief or anger, or withdraw from their regular routine. It may be difficult, but patience is the answer. Grief has no specific timeline.
Simple words to communicate to anyone grieving may be something like, “I’m here if you want to talk,” or “I understand, and am here to support you.”
Encourage kids to ask questions. One-on-one time is incredibly helpful. Provide as much stability as possible.
If you are experiencing grief, don’t run away from your feelings, and do your best to stay present. Be kind to yourself and take care of your health. Try walking, try talking. I’ve found grief can impact memory and concentration, so cut yourself some slack. Your brain only has room for so much. And trust in an upcoming renewal.
Goodbye, winter
Hello, spring!
Bye, chilled toes
Hi, green thing!
Crack, egg, crack
Sing, bird, sing!
Goodbye, winter
Hello, spring!

(From Seasons written by Raven Howell)
Raven Howell writes stories and poetry for children. Her books have garnered honors such as Creative Child Magazine’s Best Book of the Year, Mom’s Choice Award, and US Book of Review’s Most Recommended. Her poetry is published in children’s magazines, she writes the “Book Bug” column for Story Monsters Ink, and authors storybooks for ReadingGate. Her book, Seasons, was published in 2023 by Jan-Carol Publishing. Find out more at www.ravenhowell.com.
www.voicemagazineforwomen.com | April 2024 | 27
{

WhatIt’s A Classic!
Short and sweet film reviews of old, classic movies perfect for a girls’ night in!
By Allison Chudina
better movie to help celebrate spring and new beginnings than the 1964 musical classic, Mary Poppins. Starring the iconic Julie Andrews, this movie follows two young children, Jane and Michael, as they are faced with a new, fantastical nanny (Andrews) to help set them on a path of fun. As the children embark on a series of magical and musical adventures with Poppins and her Cockney performer
Kingsport Spring Spectacular Photography Contest and Exhibition Begins 22nd Year
The 22nd Annual Kingsport Spring Spectacular Photography Contest and Exhibition is ready for the talents of the photographers, who enter their works of art in 2024. The Kingsport Spring Spectacular Photography Contest and Exhibition is for absolutely everyone. Whether you have just picked up a camera for the first time or have been a photographer for years; whether you enjoy photography as a hobby or a professional, this event is for you.
The Kingsport Spring Spectacular Photography Contest and Exhibition is divided into four levels of competition: Youth, Amateur, Proficient, and now Masters. The categories are: Nature, Pictorial, and the Carrie Penley Special Theme. The Carrie Penley Special Theme category honors a woman, Creator/Organizer Ann Fortney’s mother, who loved all kinds of scavenger hunts, especially photographic scavenger hunts. Each year the theme is different. It keeps photographers on their toes and it is just plain fun. This year’s theme is: “History/Historic.” The photographs need to show “History” for example: historic re-enactments/actors, historic buildings, monuments, historic cars/trains/planes, and etc. This category is only limited by the person’s imagination. Have fun with it and think outside the box.
Participants can start delivering their entries to The Kingsport Renaissance Center at the Main Gallery (Second floor), 1200 E. Center St. Kingsport, TN 37660 during the weekdays Monday–

friend, Bert (played by Dick Van Dyke), they are able to pass on some of their nanny’s sunny attitude to their neglectful, preoccupied parents and gain a closer relationship to their father. This movie is full of extravagant musical numbers and songs that every kid at heart can enjoy, whether you’re 22 or 82. The film contains themes of starting fresh and appreciating all life has to offer, which encompasses the season of spring perfectly.
Wine Pairing:
Watch this whimsical movie with a glass of fruity red sangria in your hand, and you’ll be feeling supercalifragilisticexpialidocious.
Friday April 22–May 3, 2024 from noon till 5 p.m. and on Saturdays April 27 and May 4 from 10 a.m. till 4 p.m. Deadline is May 4, 2024 at 4 p.m. “This isn’t just a local contest,” says Ann, “I have had entries as far away as California before, so if you live outside the region/state, and want to enter, you may ship your entries to: Ann Fortney 154 W. Wanola Ave Kingsport, TN 37660.” Just be sure they reach them by the deadline.
There is an entry fee of $5.00 per entry and there are no limits on the number of entries a person may enter. All entry fees are turned back into the event in the way of monetary prizes, ribbons, and the award reception.
The judging of the competition is Saturday May 11, 2024 from 10 a.m. till finished. The judging is open to the public and will be at the Kingsport Renaissance Center. 1200 E. Center St. Kingsport, TN room 111. The times of judging each category depends on the number of entries. Ann encourages anyone wanting to watch and understand the judging process attend. She says they make it fun and interesting, not boring.
The Kingsport Spring Spectacular Photography Exhibition will be open May 19–July 1, 2024, at the Main Art Gallery and Atrium Gallery located in the Kingsport Renaissance Center. At 1200 E. Center St. Kingsport, TN during regular business hours. The Awards Reception will be held Sunday May 19, 2024 from 2–4 p.m. at the Main Art Gallery located at the Kingsport Renaissance Center.
Visit www.penjaccphoto.com for all of the details and for an application. For more information, contact Ann Fortney at 423-914-5453, by email at anniepenjacc2@aol.com, or on Facebook at: Kingsport Spring Spectacular Photography Contest and Exhibition.
28 | April 2024 | www.voicemagazineforwomen.com
www.voicemagazineforwomen.com | April 2024 | 29
30 | April 2024 | www.voicemagazineforwomen.com
SCHEDULE AN INSPECTION TODAY! VISIT OUR WEBSITE www.weknockemdead.com Bristol: 423-279-9866 • Kingsport: 423-246-1901 Johnson City: 423-274-3993 Surrounding Areas: 1-888-850-0445 • All-State Pest & Termite Control is bonded and insured in both Tennessee & Virginia • All technicians are trained, certified and screened 3133 Hwy 126 Blountville, TN 10% DISCOUNT FOR SENIORS AND VETERANS OR ACTIVE MILITARY ALL STATE PEST & TERMITE CONTROL BE HAPPY IN 2024! NO BUGS!
The goal of Sudoku is to fill a 9×9 grid with numbers so that each row, column and 3×3 section contain all of the digits between 1 and 9.
Shop our Spring Festival!
All April long we’ll be featuring special sales on some of our favorite reads for all ages!
My Favorite Season is Spring
By Patrice Wilkerson

My Favorite Season is Spring is a beautifully illustrated picture book that every child will love. Through rhythm and rhyme, take a fun and exciting journey with little Susie as she describes her favorite season. She finds so many fun things to do and she loves the outdoors, and you will too! Great engaging teaching tool for children.
Seasons
By Raven Howell
Children learn about the seasons and weather through the diversity of a year, joyfully encountering birds and butterflies, adventuring at beaches, jumping in colorful leaf piles, and dashing through the whitest winter snow.
Boil the Ocean

 By Diane Barna
By Diane Barna
How far would you go for a loved one? This question wasn't a hard one for Clavo Cruiz. He was determined to obtain justice for his wife, Maria, within a system he felt had let them both down. Follow Clavo's adventure to his native Mexico, where he hooks up with some unsavory men and winds up MIA.
JCP’s Spring Anthology Collection
Get our entire Appalachian-Inspired Short Story Collection! Five anthologies full of stories featuring strong women and stunning Appalachian settings.
Power of Understanding
By Rick Toomey, Ed.D.
Emotional intelligence influences our ability to build strong relationships and achieve our e can enhance emotional intelligence o better understand ourselves and others. This book demonstrates how powerful ers-Briggs Type Indicator (MBTI) is in er understand how personality es our behavior and the results we

Maggie the Cat Who Came Home for Christmas
By Julia Russo
Delightful illustrations bring you inside Grandpa Charlie Green’s mountainside farmhouse. Join Maggie the cat, Pip the goat, Grandpa Charlie Green, Daddy, and of course, little Wilhelmina Olive Blessing, as she tells us this sweet wintertime story. What do they do to get little Maggie home? Join the fun. Read out loud yourself or read along with others! You will love the story of Maggie, the cat who comes home for Christmas.
Gone Before Breakfast
By Jan Howery


When brothers Jackson and Brandon Taylor vanished without a trace at the airport, their girlfriends Jan and Allison are left heartbroken and confused. The women have no idea where the brothers went, or how they disappeared from the airport. After years of no clues, Jan and Allison move on with their lives. Secrets, lies, and deception abound in Gone Before Breakfast!



























“every story needs
a book”
OF UNDERSTANDING How Per sonality Influences Our Li ves www.JanCarolPublishing.com • CLICK ON “JCP BOOK STORE”
RICK TOOMEY, Ed.D.
POWER
Voice:
20 Business Women in the Appalachian Region
Share Stories of Their Jour ney to Success
Do you have a story of success to share?
Are you proud of your roots and accomplishments?
Now you can tell the world! Here’s your opportunity to share your “voice.”
In celebration of 20 y ears of being the “voice” for women in the Appalachian Region, Vo ice Magazine for Wo me n and Jan-Carol Publishing a re teaming up for a one-of-a-kind project. We are inviting twenty business and/or career women to share their inspirational stories of struggles, challenges, and successes. Yo ur stories w ill be part of the b ig picture for inspiring other women to pursue their dreams, i gnore the naysayers, and achieve the success that they deserve.
JCP is now accepting submissions for this debut elite book of accomplished women to share their stories. The book will be sold on Amazon and other retail outlets in print and E-book formats. The deadline is July 31.
Limited submissions accepted. See details and requirements on our website. Tell your story, show your support, and receive the recognition you deserve while encouraging other women!
423.926.9983 www.JanCarolPublishing.com submissions@jancarolpublishing.com
“every story needs a book” We
Want to Hear Your Stor y!

By Ken Heath
By Ken Heath











 By Diane Barna
By Diane Barna










